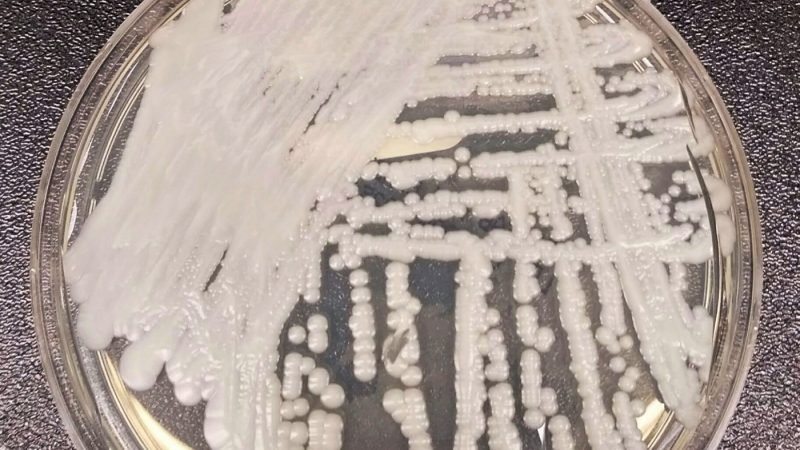

Breaking News
Here’s where the deadly fungus is spreading
(NEXSTAR) – Hospitals, nursing homes and other medical facilities are struggling to gain ground on a drug-resistant and deadly fungus that has infected at least 7,000 people in 2025, according to tracking by the Centers for Disease Control and Prevention.
Candida auris, a fungus that was first reported in the U.S. in 2016, has spread rapidly over the past several years. It can survive on surfaces for long periods of time before spreading to patients through catheters, breathing tubes or IVs.
Some strains of the fungus are considered a superbug because they’re resistant to all types of antibiotics usually used to treat fungal infections. While healthy people may be able to fight off the infection on their own, the fungus can be deadly in the health care settings where it spreads, where people are often sick and vulnerable.
Fungus labeled ‘urgent threat’ by CDC is spreading rapidly, hospital study finds
“If you get infected with this pathogen that’s resistant to any treatment, there’s no treatment we can give you to help combat it. You’re all on your own,” Melissa Nolan, an assistant professor of epidemiology and biostatistics at the University of South Carolina, told Nexstar.
The fungus’ drug resistance has made it especially hard to contain. More than half of states reported clinical cases of Candida auris in 2025, the CDC reported. With one week of data left in the year, the annual case count is approaching last year’s record-breaking figure of more than 7,500 cases.
See which states are reporting the most cases of Candida auris in the map below. Data was missing for two states: Alabama and Florida.
Some scientists theorize climate change is contributing to the spread of Candida auris and pathogens like it.
Historically, fungi have had a hard time surviving at our bodies’ warm body temperature, microbiologist Arturo Casadevall, a professor at Johns Hopkins University, told the Associated Press. But as the climate warms, the fungi are adapting.
“We have tremendous protection against environmental fungi because of our temperature. However, if the world is getting warmer and the fungi begin to adapt to higher temperatures as well, some … are going to reach what I call the temperature barrier,” where they’ll be able to survive in the human body, Casadevall said.
Candida auris: Study reveals who is most vulnerable to deadly fungus infection
In the past, the CDC estimated that “based on information from a limited number of patients, 30–60% of people with C. auris infections have died. However, many of these people had other serious illnesses that also increased their risk of death.”
A study published in July, which looked at patients with Candida auris primarily in Nevada and Florida, found more than half of patients required admission to the intensive care unit and more than one-third needed mechanical ventilation. More than half of patients, whose average age was between 60 and 64, also needed a blood transfusion.
Copyright 2025 Nexstar Media, Inc. All rights reserved. This material may not be published, broadcast, rewritten, or redistributed.
For the latest news, weather, sports, and streaming video, head to The Hill.
